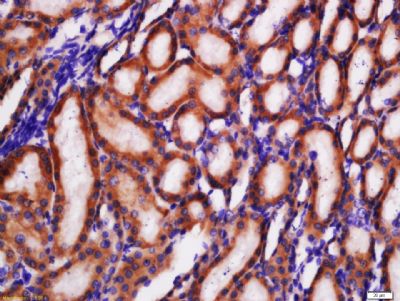
产品细节图片3

相关产品推荐更多 >
万千商家帮你免费找货
0 人在求购买到急需产品
- 详细信息
- 文献和实验
- 技术资料
- 供应商:
上海联迈生物工程有限公司
- 库存:
大量
- 目录编号:
LM-10379R
- 克隆性:
多克隆
- 抗原来源:
Rabbit
- 保质期:
1年
- 抗体英文名:
GLUT2
- 抗体名:
葡萄糖转运蛋白2抗体
- 宿主:
Rabbit
- 适应物种:
Human, Mouse, Rat, Horse,
- 免疫原:
KLH conjugated synthetic peptide derived from human GLUT2:1-100/524 <Extracellular>
- 亚型:
IgG
- 形态:
Lyophilized or Liquid
- 应用范围:
WB=1:500-2000 ELISA=1:500-1000 IHC-P=1:400-800 IHC-F=1:400-800 Flow-Cyt=1μg/Test ICC=1:100-500 IF=1:100-500 (石蜡切片需做抗原修复)
- 浓度:
1mg/ml
- 保存条件:
Store at -20 °C
- 规格:
100ul 200ul
| 英文名称 | GLUT2 |
| 中文名称 | 葡萄糖转运蛋白2抗体 |
| 别 名 | liver; Glucose Transporter 2; Glucose Transporter GLUT2; Glucose transporter type 2; Glucose transporter type 2 liver; GLUT-2; GLUT2; GLUT 2; GTR2_HUMAN; SLC2A2; Solute carrier family 2 (facilitated glucose transporter) member 2; Solute carrier family 2 facilitated glucose transporter member 2; Solute carrier family 2, facilitated glucose transporter member 2. |
| 规格价格 | 100ul/1380元 购买 200ul/2200元 购买 大包装/询价 |
| 说 明 书 | 100ul 200ul |
| 研究领域 | |
| 抗体来源 | Rabbit |
| 克隆类型 | Polyclonal |
| 交叉反应 | Human, Mouse, Rat, Horse, |
| 产品应用 | WB=1:500-2000 ELISA=1:500-1000 IHC-P=1:400-800 IHC-F=1:400-800 Flow-Cyt=1μg/Test ICC=1:100-500 IF=1:100-500 (石蜡切片需做抗原修复) not yet tested in other applications. optimal dilutions/concentrations should be determined by the end user. |
| 分 子 量 | 54kDa |
| 细胞定位 | 细胞膜 |
| 性 状 | Lyophilized or Liquid |
| 浓 度 | 1mg/ml |
| 免 疫 原 | KLH conjugated synthetic peptide derived from human GLUT2:1-100/524 <Extracellular> |
| 亚 型 | IgG |
| 纯化方法 | affinity purified by Protein A |
| 储 存 液 | 0.01M TBS(pH7.4) with 1% BSA, 0.03% Proclin300 and 50% Glycerol. |
| 保存条件 | Store at -20 °C for one year. Avoid repeated freeze/thaw cycles. The lyophilized antibody is stable at room temperature for at least one month and for greater than a year when kept at -20°C. When reconstituted in sterile pH 7.4 0.01M PBS or diluent of antibody the antibody is stable for at least two weeks at 2-4 °C. |
| PubMed | PubMed |
| 产品介绍 | background: Glucose transporter 2 isoform is an integral plasma membrane glycoprotein of the liver, islet beta cells, intestine, and kidney epithelium. It mediates facilitated bidirectional glucose transport. Because of its low affinity for glucose, it has been suggested as a glucose sensor. [provided by RefSeq, Jul 2008]. Function: Facilitative glucose transporter. This isoform likely mediates the bidirectional transfer of glucose across the plasma membrane of hepatocytes and is responsible for uptake of glucose by the beta cells; may comprise part of the glucose-sensing mechanism of the beta cell. May also participate with the Na(+)/glucose cotransporter in the transcellular transport of glucose in the small intestine and kidney. Subcellular Location: Membrane; Multi-pass membrane protein. Tissue Specificity: Liver, insulin-producing beta cell, small intestine and kidney. Post-translational modifications: N-glycosylated; required for stability and retention at the cell surface of pancreatic beta cells. DISEASE: Defects in SLC2A2 are the cause of Fanconi-Bickel syndrome (FBS) [MIM:227810]. FBS is a rare, well-defined clinical entity, inherited in an autosomal recessive mode and characterized by hepatorenal glycogen accumulation, proximal renal tubular dysfunction, and impaired utilization of glucose and galactose. Similarity: Belongs to the major facilitator superfamily. Sugar transporter (TC 2.A.1.1) family. Glucose transporter subfamily. SWISS: P11168 Gene ID: 6514 Database links: Entrez Gene: 6514 Human Entrez Gene: 20526 Mouse Entrez Gene: 25351 Rat Omim: 138160 Human SwissProt: P11168 Human SwissProt: P14246 Mouse SwissProt: P12336 Rat Unigene: 167584 Human Unigene: 18443 Mouse Unigene: 89295 Rat Important Note: This product as supplied is intended for research use only, not for use in human, therapeutic or diagnostic applications. |
| 产品图片 |  Sample: Liver (Mouse) Lysate at 40 ug Primary: Anti-GLUT2 (bs-10379R) at 1/300 dilution Secondary: IRDye800CW Goat Anti-Rabbit IgG at 1/20000 dilution Predicted band size: 54 kD Observed band size: 54 kD  Sample: Kidney (Mouse) Lysate at 40 ug Primary: Anti-GLUT2 (bs-10379R) at 1/300 dilution Secondary: IRDye800CW Goat Anti-Rabbit IgG at 1/20000 dilution Predicted band size: 54 kD Observed band size: 54 kD Tissue/cell: rat kidney tissue; 4% Paraformaldehyde-fixed and paraffin-embedded; Antigen retrieval: citrate buffer ( 0.01M, pH 6.0 ), Boiling bathing for 15min; Block endogenous peroxidase by 3% Hydrogen peroxide for 30min; Blocking buffer (normal goat serum,C-0005) at 37℃ for 20 min; Incubation: Anti-GLUT2 Polyclonal Antibody, Unconjugated(bs-10379R) 1:200, overnight at 4°C, followed by conjugation to the secondary antibody(SP-0023) and DAB(C-0010) staining  Blank control (blue line): Hep G2(fixed with 70% ethanol Overnight at 4℃). Primary Antibody (green line): Rabbit Anti-GLUT2 antibody (bs-10379R),Dilution: 1μg /10^6 cells; Isotype Control Antibody (orange line): Rabbit IgG . Secondary Antibody (white blue line): Goat anti-rabbit IgG-PE,Dilution: 1μg /test. |
风险提示:丁香通仅作为第三方平台,为商家信息发布提供平台空间。用户咨询产品时请注意保护个人信息及财产安全,合理判断,谨慎选购商品,商家和用户对交易行为负责。对于医疗器械类产品,请先查证核实企业经营资质和医疗器械产品注册证情况。
 文献和实验
文献和实验上海西唐生物科技有限公司 021-55229872, 65333639 www.westang.com 人葡萄糖转运蛋白 ( Glut-1 )ELISA 试剂盒 ( 用于血清、血浆、细胞培养上清液和其它生物体液内 ) 原理 本实验采用双抗体夹心 ABC-ELISA 法。用抗人 Glut-1 单抗包被于酶标板上,标准品和样品中的 Glut-1与单抗结合,加入生物
Cancer Cell:曹雪涛院士团队揭示肿瘤相关巨噬细胞中葡萄糖代谢的增加可促进癌症转移
意义。 图片来源:Cancer Cell 主要研究内容 M2 样 TAMs 在 TME 中具有较高的葡萄糖摄取能力 为了鉴定 TAMs 中特异表达的基因,他们对其进行了单细胞转录组测序(scRNA-seq)。通过细胞聚类分析,他们区分了浸润性单核细胞、M1 样和 M2 样巨噬细胞,以及髓系祖细胞。他们注意到 Slc2a1(也被称为 Glut1)在 M2 样 TAMs 中特异性高表达,Glut1 是巨噬细胞中主要的葡萄糖转运蛋白。此外,与腹膜和脾脏巨噬细胞和外周血单核细胞相比,TAMs 在体
警惕!塑料中的这种化学物质可改变精子,对健康的危害竟会延续两代
,接触 DCHP 的 F0 亲本所产生的 F2 后代小鼠中,只有雌性而非雄性小鼠表现出糖耐量受损,但胰岛素耐量结果相当,这表明父本接触 DCHP 对后代代谢健康具有性别特异性的跨代影响。 他们还分析了肝脏基因表达,以了解在 F2 雌性小鼠中葡萄糖不耐受表型的潜在机制,结果发现,包括 Glut2 和 Tlr8 在内的几个基因,在 F1 小鼠中被父系 DCHP 暴露改变,但在 F2 小鼠中没有改变;不过,另一个葡萄糖转运蛋白家族基因 Glut9 在 F2 雌性小鼠的肝脏中被父系 DCHP 暴露显著
 技术资料
技术资料暂无技术资料 索取技术资料










